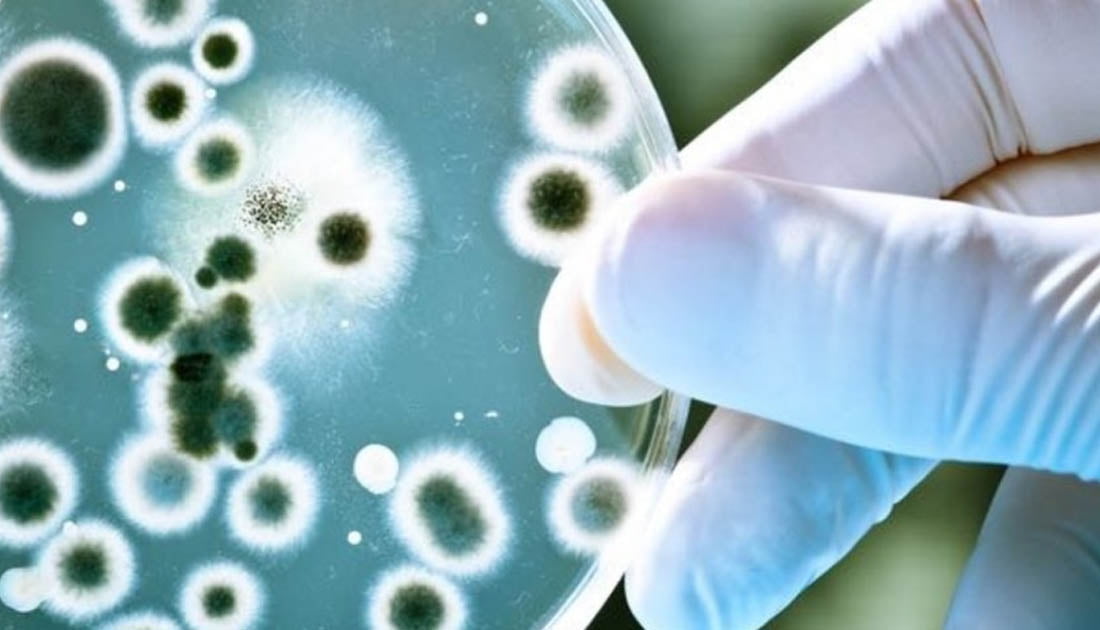

Artículo publicado en Putno Biz
En el marco de la entrada en vigencia de la Ley de Biotecnología que aporta incentivos para mejorar la competitividad, viabilizar inversiones y favorecer la innovación, la Cámara Argentina de Biotecnología (CAB) anunció inversiones por 700 millones de dólares en el sector, y entre ellas se encuentra la biotecnológica rosarina Wiener lab.
Como antecedente, en agosto del año 2017 el presidente Mauricio Macri firmó con el sector un Acuerdo de Biotecnología destinado a la promoción y el desarrollo de la biotecnología, en el cual diversas empresas se comprometieron a un plan de inversión para el período 2017-2019.
Leer también
El Gobierno reglamentó la Ley de Biotecnología y se espera un impacto positivo en empresas
En ese marco, las inversiones anunciadas el día viernes al ministro de Producción Francisco Cabrera por las empresas biotecnológicas estarán destinadas a proyectos como biotecnología aplicada a la salud, sanidad animal, alimentos y agrobiotecnología, entre otros.
Las inversiones provendrán de varias firmas argentinas. Entre las más relevantes se encuentran Mabxience (40 millones para una nueva planta), Sinergium Biotech, (50 millones para una nueva planta y 40 millones para una nueva línea de llenado) y Laboratorio Gador (79 millones para la ampliación de la planta actual y creación de una planta nueva)
Leer también
Monsanto planea lanzar en Brasil la soja resistente a dicamba
A su vez, en la lista aparece también una representante rosarina. La empresa biotecnológica Wiener lab anunció una inversión de un millón de dólares destinado al desarrollo biotecnológico de proteínas recombinantes para el diagnóstico de enfermedades infecciosas.
Wiener lab cuenta con más de 50 años de experiencia en el mercado de la salud, a través de la elaboración de productos dirigidos a los laboratorios de análisis clínicos y bancos de sangre. Es líder en su segmento en Latinoamérica , con distribuidores en toda la región y empresas asociadas en Brasil, Chile, Colombia, Costa Rica, México, Perú, Uruguay, República Dominicana y Venezuela.